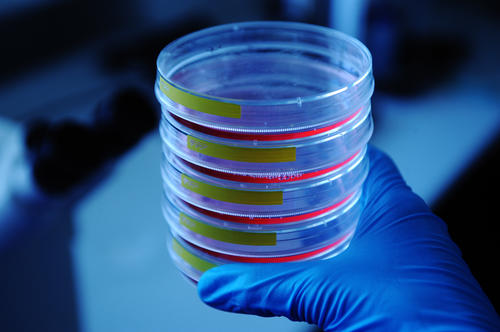
The Dahlem Research School Molecular Science grew out of an initiative of the Departments of Biology, Chemistry, Pharmacy and of Physics,

DRS Graduate School "Molecular Science"
The Dahlem Research School Molecular Science grew out of an initiative of the Departments of Biology, Chemistry, Pharmacy and of Physics,
Image Credit: David Ausserhofer
The Dahlem Research School Molecular Science grew out of an initiative of the Departments of Biology, Chemistry, Pharmacy and of Physics, it is a structured doctoral program in the rather broad area of molecular research. Collaborative Research Centres, Research Training Groups etc. offer interdisciplinary seminars, and additional training in presentation seminars and workshops is provided as part of the vocational training, thus preparing doctoral candidates for their later work in international and multidisciplinary environments. The language of science is English, but for better integration, international candidates with a poor knowledge of German are offered the opportunity to follow German language classes on various levels and to become acquainted with German and European culture. Exercises in speaking in public, techniques of rhetoric, planning and carrying out scientific research projects, and the organization of workshops and conferences are also on the schedule.
As a rule, it will take three years to complete the doctoral program, each student has two supervisors. Regular seminars and reports by the students, as agreed upon in the tuition contract, will serve the purpose of quality control.
The research areas encompass the investigation of small molecules with respect to their dynamics and as model substances for larger entities, molecular architecture and biomolecules in complex environments. Key notions are:
-
Simulation of molecular processes
-
Nanoscale functional materials, molecular switches